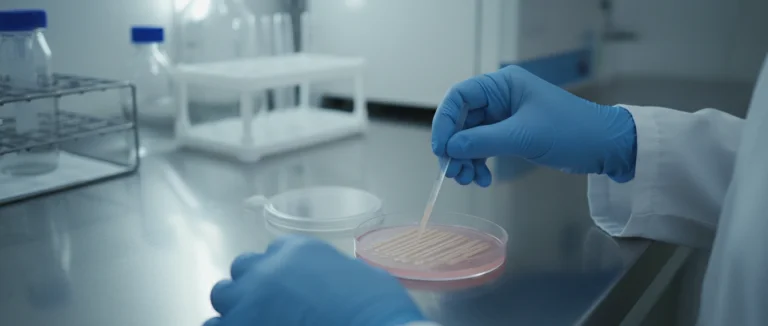
Лабораторный анализ мочи

Escherichia coli в моче: причины, симптомы и лечение
-
Что такое Escherichia coli и как она попадает в мочевой тракт?
-
Клинические проявления: симптомы и признаки инфекции
-
Диагностика: как выявить Escherichia coli в моче
-
Лечение и профилактика: эффективные стратегии
-
Почему стоит выбрать Лив Хоспитал
Появление Escherichia coli в моче является одной из самых распространённых причин инфекций мочевых путей (УТИ). Эта бактерия, известная также как кишечная палочка, может вызвать от лёгкого дискомфорта до тяжёлых осложнений, если её не выявить и не лечить своевременно. По данным международных исследований, более 70 % всех случаев УТИ у женщин связаны именно с Escherichia coli. В статье мы разберём, как происходит заражение, какие симптомы указывают на наличие бактерии в моче, какие методы диагностики применяются в современной медицине и какие варианты лечения доступны в Лив Хоспитал.
Среди иностранных пациентов, обращающихся за помощью, частой проблемой является отсутствие своевременного доступа к качественной диагностике. Неправильный выбор антибиотика или задержка в начале терапии могут привести к распространению инфекции на почки и развитию пиелонефрита. Поэтому важно знать, как распознать первые признаки и какие шаги предпринять, чтобы быстро восстановить здоровье.
В дальнейшем мы подробно рассмотрим биологию бактерии, пути её попадания в мочевой тракт, клинические проявления, современные лабораторные методы выявления и доказательно обоснованные схемы лечения, включая рекомендации по профилактике рецидивов.
Что такое Escherichia coli и как она попадает в мочевой тракт?
Escherichia coli — грамоотрицательная бактерия, естественно обитающая в кишечнике человека и животных. При нормальном состоянии она не вызывает заболеваний, однако при нарушении баланса микрофлоры или при миграции в другие части организма может стать патогеном.
Бактериальная природа
Кишечная палочка обладает рядом факторов вирулентности: адгезины, которые позволяют ей прикрепляться к эпителиальным клеткам, и токсины, вызывающие воспаление. Эти свойства делают её способной колонизировать уретру и мочевой пузырь.
Пути заражения
- Эндогенное перемещение: бактерии из кишечника попадают в уретру при неправильной гигиене.
- Экзогенные источники: контакты с загрязнёнными предметами, неправильное использование катетеров.
- Половой акт: передача бактерий от партнёра.
У женщин анатомические особенности (короткая уретра) повышают риск миграции Escherichia coli в мочевой тракт, тогда как у мужчин инфекция часто связана с обструкциями или камнями в почках.

Клинические проявления: симптомы и признаки инфекции
Симптомы, связанные с наличием Escherichia coli в моче, могут варьироваться от лёгкого дискомфорта до выраженной боли и лихорадки. Ниже перечислены наиболее типичные проявления УТИ, вызванные этой бактерией.
- Частое позывание, иногда с небольшим объёмом мочи.
- Жжение и боль при мочеиспускании.
- Помутнение мочи, иногда с запахом.
- Боль в нижней части живота или в пояснице (при распространении инфекции на почки).
- Лихорадка, озноб и общее недомогание.
Важно отметить различия в симптоматике у мужчин и женщин. Ниже представлена таблица сравнения.
| Признак | У женщин | У мужчин |
|---|---|---|
| Частое позывание | Да | Да, но реже |
| Жжение при мочеиспускании | Часто | Реже |
| Боль в пояснице | Если есть пиелонефрит | Чаще при осложнённой инфекции |
| Лихорадка | Редко при простом УТИ | Более вероятно |
Если вы замечаете несколько из перечисленных признаков, особенно в сочетании с повышенной температурой, рекомендуется незамедлительно пройти обследование. Раннее выявление Escherichia coli в моче позволяет избежать развития тяжёлых осложнений, таких как абсцесс почки.

Диагностика: как выявить Escherichia coli в моче
Точная диагностика является ключевым этапом в лечении УТИ. Современные лабораторные методы позволяют быстро определить наличие Escherichia coli и оценить её чувствительность к антибиотикам.
Анализ мочи (общий и посев)
Первичный скрининг включает общий анализ мочи, где обнаруживается пиурия (наличие лейкоцитов) и бактериемия. Однако для точного определения вида бактерии необходим посев мочи. В посеве обычно берут 10 мл чистой мочи, инокулируют на питательные среды и incubate 24–48 часов.
Критерии значимости роста
Согласно рекомендациям, рост Escherichia coli более 10⁵ КОЕ/мл считается клинически значимым, однако у женщин с выраженными симптомами иногда достаточно 10³ КОЕ/мл.
| Метод | Время получения результата | Информативность |
|---|---|---|
| Общий анализ мочи | 15–30 минут | Выявление пиурии и бактерий |
| Посев мочи | 24–48 часов | Определение вида бактерии и чувствительности |
| Молекулярные тесты (PCR) | 4–6 часов | Быстрое выявление генов резистентности |
В Лив Хоспитал применяется комплексный подход: помимо классического посева, используется автоматизированный анализатор для ускоренного определения чувствительности к антибиотикам, что позволяет подобрать оптимальную терапию уже в первые сутки после поступления пациента.
Лечение и профилактика: эффективные стратегии
Терапия УТИ, вызванной Escherichia coli, основывается на выборе правильных антибиотиков и поддерживающих мер. С учётом растущей резистентности к традиционным препаратам, важна индивидуальная чувствительность бактерии.
Антибиотикотерапия
- Нитрофурантоин – часто первая линия при отсутствии резистентности.
- Фосфомицин – однократный приём, удобен для амбулаторного лечения.
- Кипрофлоксацин и левофлоксацин – применяются при подтверждённой чувствительности.
- Триметоприм‑сульфаметоксазол – эффективен, но требуется проверка на аллергию.
Курс лечения обычно длится 3–7 дней, но в случае осложнённого пиелонефрита может быть продлён до 14 дней. Важно завершить курс полностью, даже если симптомы исчезли ранее.
Поддерживающие меры
- Увеличение потребления воды (не менее 2 литров в сутки) для «промывания» мочевого пузыря.
- Регулярное опорожнение мочевого пузыря, особенно после полового акта.
- Избегать раздражающих средств: ароматизированные гели, спреи.
- Поддержание нормальной микрофлоры кишечника (пробиотики).
Профилактика рецидивов также включает оценку факторов риска: диабет, анатомические аномалии, частое использование катетеров. При повторных инфекциях врач может рекомендовать длительные профилактические дозы антибиотиков или вакцинные стратегии, находящиеся в стадии клинических испытаний.
Почему стоит выбрать Лив Хоспитал
Лив Хоспитал – аккредитованная JCI сеть частных больниц в Стамбуле, специализирующаяся на комплексном обслуживании иностранных пациентов. Мы предлагаем современную диагностику Escherichia coli в моче с использованием автоматизированных систем, индивидуальный подбор антибиотикотерапии и поддержку переводчика на всех этапах лечения. Команда опытных урологов и инфекционистов обеспечивает быстрый переход от диагностики к терапии, а наши международные координаторы помогают организовать транспорт, проживание и последующее наблюдение. Выбирая Лив Хоспитал, вы получаете гарантированный уровень качества, комфорт и полное сопровождение на английском и других языках.
Если вы подозреваете инфекцию мочевых путей или хотите пройти полное обследование, свяжитесь с нами прямо сейчас. Наши специалисты подготовят персонализированный план лечения и обеспечат всю необходимую поддержку на пути к выздоровлению.
Часто задаваемые вопросы
Escherichia coli естественно обитает в кишечнике. При эндогенном перемещении, например из‑за плохой личной гигиены, бактерия может мигрировать в уретру и мочевой пузырь. Экзогенные источники включают загрязнённые предметы и неправильное использование катетеров. Половой акт также способствует передаче бактерий от партнёра. У женщин короткая уретра повышает риск, у мужчин часто сопутствуют обструкции или камни.
Классические проявления включают учащённое позывание небольшими объёмами мочи, жжение и боль при мочеиспускании, помутнение мочи с характерным запахом. При распространении инфекции на почки появляется боль в пояснице, лихорадка, озноб и общее недомогание. У женщин симптомы обычно более выражены, у мужчин – реже, но более тяжёлые при осложнённом течении.
Первый шаг – общий анализ мочи, где выявляются лейкоциты и бактерии. Для точного определения вида бактерии берут 10 мл чистой мочи и проводят посев на питательные среды, получая результат через 24–48 часа. Рост более 10⁵ КОЕ/мл считается клинически значимым, хотя у женщин с ярко выраженными симптомами достаточно 10³ КОЕ/мл. Современные лаборатории используют также PCR‑тесты для быстрого определения генов резистентности (4–6 часов).
Первая линия – нитрофурантоин, если нет резистентности. Фосфомицин удобен однократным приёмом в амбулаторных условиях. При подтверждённой чувствительности применяют фторхинолоны (кипрофлоксацин, левофлоксацин). Триметоприм‑сульфаметоксазол эффективен, но требует проверки на аллергию. Длительность курса обычно 3–7 дней, при осложнённом пиелонефрите – до 14 дней. Важно завершить курс полностью, даже если симптомы исчезли.
Профилактика включает пить не менее 2 литров воды в сутки для «промывания» мочевого пузыря, опорожнение после полового акта, отказ от ароматизированных гелей и спреев, а также приём пробиотиков для поддержания здоровой кишечной микрофлоры. При наличии факторов риска (диабет, анатомические аномалии, частое использование катетеров) врач может назначить длительные профилактические дозы антибиотиков или рассмотреть участие в клинических испытаниях вакцин.
Лив Хоспитал – сеть частных больниц в Стамбуле, аккредитованная JCI, специализирующаяся на обслуживании иностранных пациентов. В клинике применяется автоматизированный анализатор для быстрого определения чувствительности бактерий к антибиотикам, что позволяет подобрать оптимальную терапию в первые сутки. Команда урологов и инфекционистов обеспечивает комплексный подход, а международные координаторы помогают с транспортом, проживанием и последующим наблюдением, предоставляя поддержку на английском и других языках.
* Содержимое нашего сайта предназначено только для информационных целей. Обязательно обратитесь к врачу для диагностики и лечения. В содержание страницы не включены элементы, содержащие информацию о терапевтических медицинских услугах в Лив Госпитале.












